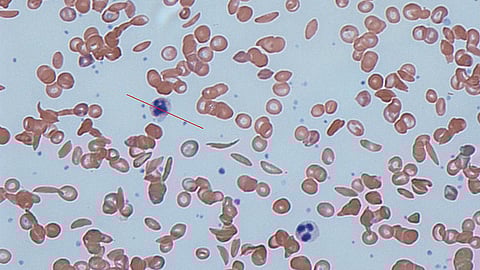
Sickle cells in human blood - both normal red blood cells and sickle-shaped cells are present. (Photo | Wikimedia Commons)

Sickle Cell Disease (SCD) is a serious genetic disorder with significant implications on morbidity and mortality across the world. Globally, an estimated 7% of the population carries an abnormal haemoglobin gene, leading to about 3,00,000-5,00,000 annual births with major haemoglobin disorders.
Sickle cell is the most prevalent disorder, accounting for 70% of births with haemoglobinopathies worldwide.
India is among the worst- affected countries in the world with SCD widespread across states. SCD contributes significantly to high infant mortality, maternal mortality rate and anaemia apart from inflicting huge socio- economic burden. The prevalence of SCD (both carrier and homozygous trait) varies widely across the population from 1 to 44%. This disease mainly affects the population of central India and many states like Odisha (16.69%), Chhattisgarh (12.1%), Gujarat (14.7%), Rajasthan (18.25%), Maharashtra (14%) and Madhya Pradesh (17.5%)
Mass screening of the population of 14 districts under Odisha Sickle Cell & Thalassemia Control Programme has detected Sickle Cell gene among 12.5% of the population out of which 1% belongs to disease category (homozygous trait) and rest Sickle Cell carrier type.
The Sickle Cell Trait has been historically witnessed predominantly among tribal populations. However, with opening up of the society and exposure of tribals to the outer world, migration and inter-community communion has led to spread of SCD in non-tribal groups across castes and economic class.
Understanding Sickle Cell Disease
SCD involves a group of inherited red blood cell disorders caused by defective haemoglobin genes. The sickle-shaped cells with reduced ability to carry oxygen, lead to chronic oxygen deprivation and potential tissue and organ damage. The cells cause blockages in blood flow, resulting in severe pain, a condition known as pain crisis. Individuals with defective haemoglobin genes from both parents develop Sickle Cell Anaemia (SCA), a severe form of the disease. Those who inherit the gene from one parent are called carriers, a condition termed Sickle Cell Trait (SCT), which typically does not present severe symptoms.
The symptoms of SCA include anaemia, jaundice, severe pain episodes, breathlessness, fatigue, recurrent infections, complications during pregnancy, organ damage, etc. Managing SCA involves regular medical consultations, staying hydrated, adhering to prescribed medications, maintaining a balanced diet, avoiding extreme weather conditions and high altitudes, and providing additional care for children, including special vaccinations and routine follow-ups.
Early Diagnosis and Awareness
Like any other serious disease, early diagnosis of SCD is the key. In SCD it assumes more significance as early detection impacts future generations. Sickle cell carriers in a substantial chunk of cases do not have any symptoms throughout their lives, and in the process transmit it to their progeny who undergo the complications. Knowing one’s status, thus, will not only help in getting treated but also prevent inter-generational transmission.
Increasing awareness about SCD is crucial for the early diagnosis and effective management of this debilitating condition. By educating communities and healthcare professionals about the symptoms and challenges associated with SCD, we can promote timely interventions. Improving access to quality healthcare services and development of new therapies and medicines is vital in the fight against SCD. Policymakers, healthcare providers, researchers, and the general public must collaborate to address the disparities in care and support innovative treatment options.
Eradicating Social Stigma First
Along with the physical manifestations, social stigma is also one of the most excruciating aspects of SCD where the exclusion faced by a patient leads to psychological distress and affects mental well-being. Various misconceptions and misunderstandings about the disease keep the patient out of the mainstream and deprive them of social, educational, employment and even familial participation. The stigma leads the patients to hide their condition. Addressing this issue requires comprehensive public education to dispel myths and promote a more inclusive and supportive environment for people living with SCD.
The Mission to Eliminate Sickle Cell Anaemia by 2047
In an ambitious move, the Union government has announced a mission to eradicate SCA by 2047. The mission aims to create awareness, conduct universal screening for 7 crore people aged 0-40 years in affected tribal areas. The initiative focuses on early detection, comprehensive management, and prevention of the disease. A significant milestone has been achieved with over 1 crore individuals screened under the National Sickle Cell Anaemia Elimination Mission.
However, much more is needed to address the significant health challenges posed by SCD, particularly among vulnerable tribal populations, and improve the overall health scenario in India.
Prof RK Jena
(The writer is Professor of Clinical Hematology, SCB Medical College and Hospital, Cuttack and Secretary, Indian College of Hematology)